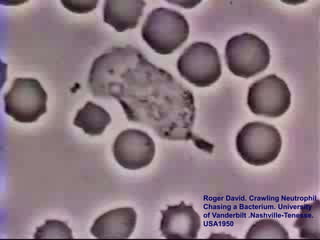
Aggressive Periodontitis

Incrustar presentación
Descargado 222 veces



















































































































































Este documento presenta información sobre periodontitis agresivas. Brevemente resume que la periodontitis agresivas se caracteriza por una destrucción periodontal rápida y severa en personas mayormente jóvenes y sanas. Menciona que la causa principal es la presencia de bacterias patógenas como Aggregatibacter actinomycetemcomitans. Finalmente, indica que tiene una mayor prevalencia en personas de raza caucásica, hispana y afroamericana en comparación con personas de raza china.